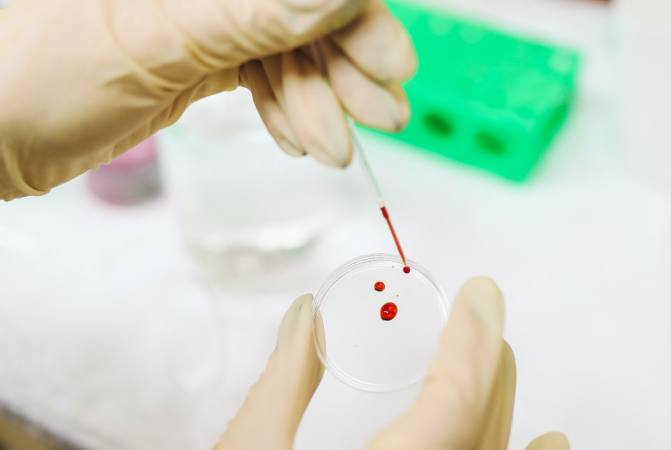

La Organización Panamericana de la Salud (OPS) instó este miércoles a los países de Latinoamérica a empezar a utilizar un nuevo test rápido para detectar el Covid-19 y dijo que está realizando una prueba piloto en regiones remotas de Ecuador, El Salvador, México y Surinam.
Reveló, asimismo, que trabaja junto a las autoridades de Venezuela para llevar el nuevo test de antígenos a zonas que no pueden acceder fácilmente a las pruebas de laboratorio.
“Me complace informar que ha llegado uno de estos avances que podría cambiar las reglas del juego en nuestra región”, expresó la directora de la OPS, Clarissa Etienne, en la rueda de prensa virtual semanal de la organización desde Washington. “Ahora tenemos una prueba de diagnóstico asequible y confiable que se puede realizar en cualquier lugar”, agregó.
El nuevo test, que fue aprobado en septiembre por la Organización Mundial de la Salud (OMS), es fabricado por dos compañías diferentes: una con sede en Asia y la otra con sede en Europa y Estados Unidos. La OPS no reveló sus nombres ni el de la prueba.
Las Américas han sido el epicentro de la epidemia durante meses, con más de 18 millones de casos de coronavirus y más de 590.000 muertos.
Más de la mitad de esos casos, 10 millones, han sido reportados en Latinoamérica, donde también se han registrado más de 370.000 decesos, según el Centro de Ciencia e Ingeniería de Sistemas de la Universidad Johns Hopkins.
En las últimas semanas la pandemia se ha trasladado a zonas menos pobladas. En Guatemala, por ejemplo, se han triplicado las muertes en el departamento de Petén, mientras que en Bolivia la mayor incidencia está en el departamento de Tarija.
En Argentina, en tanto, los casos siguen incrementándose y llegaron a 16.000 por día la semana pasada, según registros de la OPS.
Existen por ahora dos maneras de acceder a las nuevas pruebas: a través de programas pilotos y por medio de un fondo estratégico de la OPS en el que pueden participar los países para asegurar su obtención, de la misma manera que ya lo hacen con algunas medicinas.
La OPS dijo que tiene cientos de miles de esas pruebas en sus depósitos en Panamá y espera la llegada de millones más en las próximas semanas.
Etienne explicó que ya están ayudando a los países a implementar nuevos protocolos para que los trabajadores sanitarios sepan cómo usar los nuevos test.
En el caso de las pruebas piloto, la OPS suministrará los test sin costo y vigilará su utilización.
“Insto a los Estados miembros a que se asocien con la OPS para llevar estas nuevas pruebas a los hospitales y clínicas”, dijo Etienne, pero destacó que no reemplazan a los test PCR, que son los más confiables hasta este momento.
En Latinoamérica se han distribuido pruebas económicas de diagnóstico rápido que no cuentan con el aval de la OPS, que las considera poco confiables. Generalmente miden el nivel de anticuerpos en la sangre y por eso en etapas tempranas suelen no detectar la enfermedad.
Las pruebas de PCR, en cambio, detectan la presencia del virus en el cuerpo y son sumamente precisas. Pero como deben realizarse en laboratorios, generalmente sus resultados toman semanas en áreas de difícil acceso como regiones montañosas, desiertos e islas. Así, personas que están enfermas suelen seguir con su rutina normal mientras esperan los resultados, visitando a familiares y utilizando el transporte público, lo que ayuda a propagar el contagio, según la OPS.
Los test de antígenos, por su parte, detectan proteínas específicas del coronavirus y sus resultados pueden estar en menos de una hora, según la Facultad de Medicina de la Universidad de Harvard. Si dan positivos, es muy probable que la persona esté enferma, pero si dan negativos, es posible que los médicos recomienden una prueba de PCR.
Las nuevas pruebas permiten aislar a los enfermos rápidamente y comenzar los tratamientos de inmediato, dijo Etienne. El diagnóstico se puede hacer en cuestión de minutos, en lugar de días, y a un tercio del costo de las pruebas de PCR, explicó.
En el caso de Venezuela, las pruebas de antígenos ya están allí, dijo Ciro Ugarte, director de emergencias de la OPS, y explicó que permitirán acelerar los diagnósticos en áreas donde los resultados de los exámenes moleculares suelen tomar dos semanas.
A Ecuador, en cambio, aún no han llegado los tests, pero ya se trabaja con las autoridades y la red de laboratorios para implementarlos en siete áreas prioritarias remotas de poblaciones indígenas y afrodescendientes, dijo Sylvain Aldighieri, gerente de incidente para COVID-19 de la organización.
No se ofrecieron detalles sobre los programas de El Salvador y Surinam.
Miami / AP



